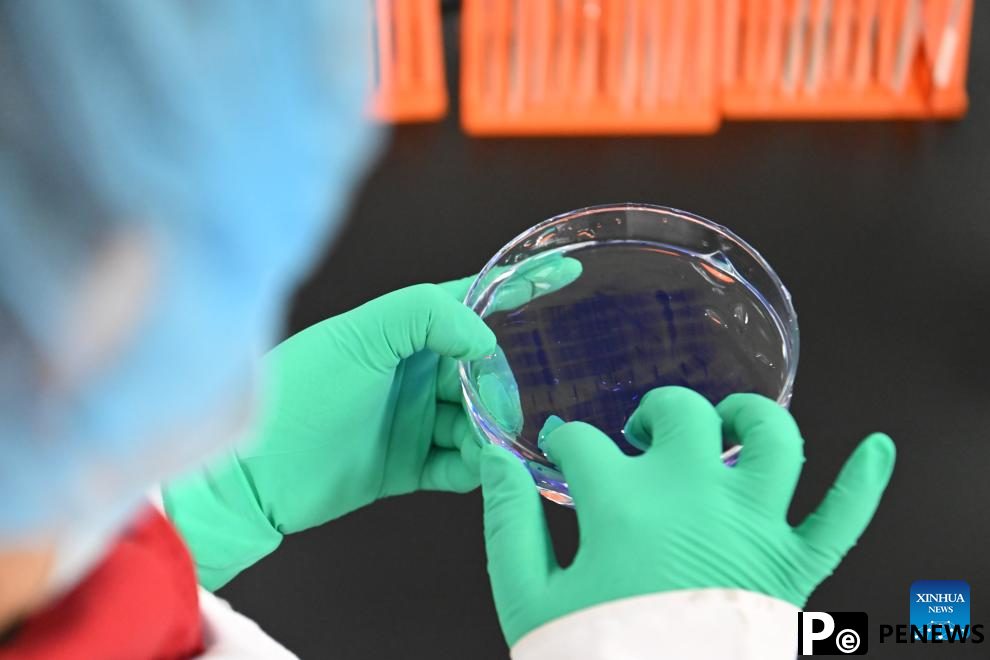
Tianjin Zhongguancun Tech Town registers market players of various types

Home>>
Beijing-Tianjin Zhongguancun Tech Town registers market players of various types(Xinhua) 08:18, February 25, 2025

This photo taken on Feb. 20, 2025 shows a monitoring robot at Tianjin SIASUN Intelligent Technology Co., Ltd. in the Beijing-Tianjin Zhongguancun Tech Town, in Tianjin, north China.
As a key cooperation platform for Beijing and Tianjin to jointly implement the national strategy for the coordinated development of Beijing-Tianjin-Hebei region, and the first asset-heavy project of Zhongguancun outside Beijing, the Beijing-Tianjin Zhongguancun Tech Town has registered a total of 1,800 market players of various types, including enterprises of information technology, high-end equipment manufacturing and biomedicine. (Xinhua/Sun Fanyue)
A staff member checks the condition of a petri dish at a biomedical company in the Beijing-Tianjin Zhongguancun Tech Town, in Tianjin, north China, Feb. 20, 2025.
As a key cooperation platform for Beijing and Tianjin to jointly implement the national strategy for the coordinated development of Beijing-Tianjin-Hebei region, and the first asset-heavy project of Zhongguancun outside Beijing, the Beijing-Tianjin Zhongguancun Tech Town has registered a total of 1,800 market players of various types, including enterprises of information technology, high-end equipment manufacturing and biomedicine. (Xinhua/Sun Fanyue)

Staff members compare experiment data at a biomedical company in the Beijing-Tianjin Zhongguancun Tech Town, in Tianjin, north China, Feb. 20, 2025.
As a key cooperation platform for Beijing and Tianjin to jointly implement the national strategy for the coordinated development of Beijing-Tianjin-Hebei region, and the first asset-heavy project of Zhongguancun outside Beijing, the Beijing-Tianjin Zhongguancun Tech Town has registered a total of 1,800 market players of various types, including enterprises of information technology, high-end equipment manufacturing and biomedicine. (Xinhua/Sun Fanyue)

An aerial drone photo taken on Feb. 24, 2025 shows a view of the Beijing-Tianjin Zhongguancun Tech Town in Tianjin, north China.
As a key cooperation platform for Beijing and Tianjin to jointly implement the national strategy for the coordinated development of Beijing-Tianjin-Hebei region, and the first asset-heavy project of Zhongguancun outside Beijing, the Beijing-Tianjin Zhongguancun Tech Town has registered a total of 1,800 market players of various types, including enterprises of information technology, high-end equipment manufacturing and biomedicine. (Xinhua/Li Ran)

An aerial drone photo taken on Feb. 24, 2025 shows a view of the Beijing-Tianjin Zhongguancun Tech Town in Tianjin, north China.
As a key cooperation platform for Beijing and Tianjin to jointly implement the national strategy for the coordinated development of Beijing-Tianjin-Hebei region, and the first asset-heavy project of Zhongguancun outside Beijing, the Beijing-Tianjin Zhongguancun Tech Town has registered a total of 1,800 market players of various types, including enterprises of information technology, high-end equipment manufacturing and biomedicine. (Xinhua/Li Ran)

An aerial drone photo taken on Feb. 24, 2025 shows a view of the Beijing-Tianjin Zhongguancun Tech Town in Tianjin, north China.
As a key cooperation platform for Beijing and Tianjin to jointly implement the national strategy for the coordinated development of Beijing-Tianjin-Hebei region, and the first asset-heavy project of Zhongguancun outside Beijing, the Beijing-Tianjin Zhongguancun Tech Town has registered a total of 1,800 market players of various types, including enterprises of information technology, high-end equipment manufacturing and biomedicine. (Xinhua/Li Ran)

Staff members check a patrol robot at Tianjin SIASUN Intelligent Technology Co., Ltd. in the Beijing-Tianjin Zhongguancun Tech Town, in Tianjin, north China, Feb. 20, 2025.
As a key cooperation platform for Beijing and Tianjin to jointly implement the national strategy for the coordinated development of Beijing-Tianjin-Hebei region, and the first asset-heavy project of Zhongguancun outside Beijing, the Beijing-Tianjin Zhongguancun Tech Town has registered a total of 1,800 market players of various types, including enterprises of information technology, high-end equipment manufacturing and biomedicine. (Xinhua/Sun Fanyue)

An aerial drone photo taken on Feb. 24, 2025 shows a view of the Beijing-Tianjin Zhongguancun Tech Town in Tianjin, north China.










